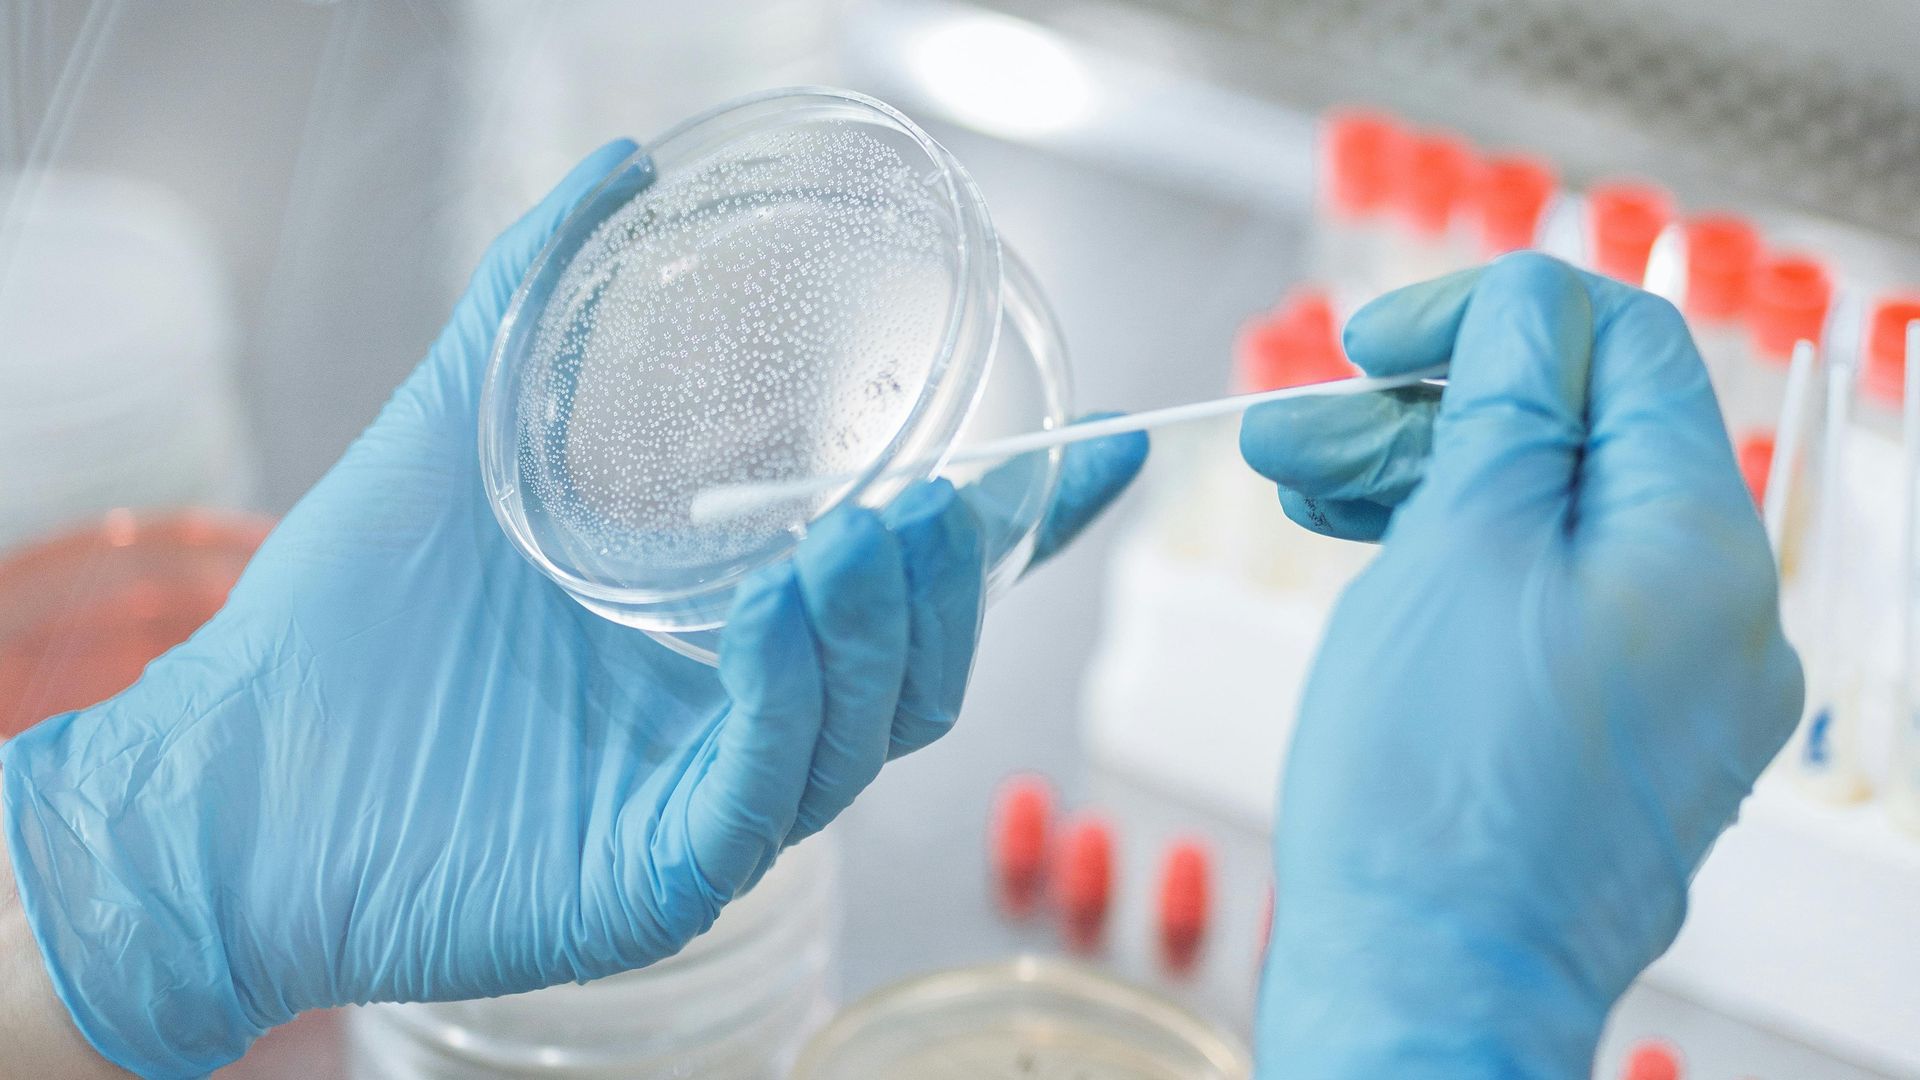

Una mujer demuestra que su padre es un empresario suizo gracias a que coincidieron en un banco de ADN
Una mujer residente en Las Palmas de Gran Canaria demuestra que su padre es un empresario suizo gracias a coincidir con él en un banco de ADND
Una pareja estadounidense descubre que su bebé no es suyo: la clínica de fecundación in vitro se equivocó de embrión
Una mujer de nacionalidad española-guineana residente en Las Palmas de Gran Canaria ha conseguido demostrar que es hija de un empresario suizo, tras cruzarse casualmente sus pruebas de ADN en el banco en el que ambos lo habían depositado con años de diferencia.
El abogado de la mujer, el sevillano Fernando Osuna, ha explicado que a EFE que la mujer presentó una demanda de paternidad que ahora ha sido avalada por un juzgado, sin haber presentado inicialmente pruebas físicas de la relación entre ambos.
Sin embargo, en 2017 la demandante se dio de alta en una entidad a la que se puede enviar el ADN mediante una prueba de saliva, con el fin de conocer los orígenes genéticos de las personas, con la casualidad de que su entonces supuesto padre había hecho lo mismo años antes.
Un proceso judicial de más de cinco años
Con esa prueba presentó una demanda, que le ha servido para que la Audiencia Provincial de Las Palmas le haya dado la razón, revocando la decisión del juzgado de primera instancia que consideró que no tenía razón en la demanda.
La demanda cierra un largo proceso judicial, culminado tras cinco años, en el que la mujer ha intentado encontrar a su progenitor, sin éxito, tras conocerse su madre y su padre años atrás en Las Palmas,
La mujer citaba en su demanda que su padre mantuvo con ella una relación "de armonía" hasta que le pidió que la reconociese como hija, y tras buscarle en redes sociales y por distintas vías finalmente le localizó gracias a un banco de ADN.